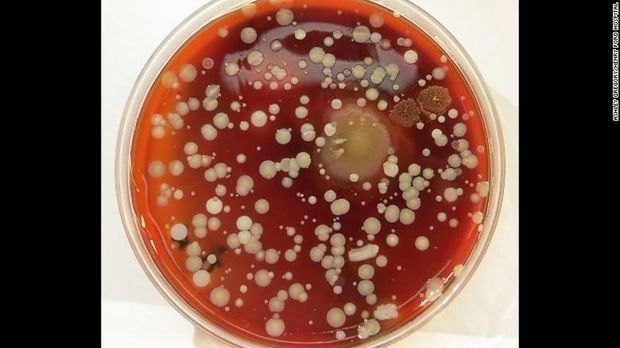

Tim dari Henry Ford Health System mengatakan tingkat cuci tangan petugas kesehatan di rumah sakit di Detroit membaik setelah diperlihatkan gambar jutaan bakteri di permukaan aneka benda. Benda-benda itu antara lain sarung tangan yang tidak digunakan, pegangan pintu, tangan petugas kesehatan, juga ponsel dan mesin ultrasound.
"Kebersihan tangan merupakan salah satu cata yang paling penting untuk mencegah penyebaran infeksi. Dan (kebiasaan) ini merupakan hal yang paling sulit untuk ditingkatkan," ujar Susan Dolan, Presiden Association for Professionals in Infection Control and Epidemiology. Demikian dilansir CNN.
ADVERTISEMENT
SCROLL TO CONTINUE WITH CONTENT
Gambar bakteri (Foto: CNN) Gambar bakteri (Foto: CNN) |
Gambar-gambar tersebut telah diuji beberapa kali selama dua bulan di empat rumah sakit yang dianggap memiliki kepatuhan mencuci tangan yang rendah. Setelah melihat gambar bakteri, diketahui kebiasaan mencuci tangan meningkat 11 persen di salah satu RS. Sementara itu di RS lainnya bahkan meningkat hingga 50 persen.
"Staf RS ingin mencuci tangannya setelah melihat buku dan membayangkan kontaminasi serupa di kulit mereka," ujar Ashley Gregory, seorang spesialis pencegahan infeksi yang ikut memimpin kegiatan tersebut.
Meski sering dianggap remeh, cuci tangan menggunakan sabun bisa membantu mengurangi penyebaran infeksi, misalnya saja infeksi virus flu. Apalagi tangan memiliki jumlah kuman yang paling banyak. Sebab tangan manusia berfungsi sebagai indra peraba dan sering menyentuh benda-benda asing, sehingga tak menutup kemungkinan bisa menjadi sarang kuman.
Untuk masyarakat umum cuci tangan pakai sabun dianjurkan dilakukan sebelum makan dan sesusah BAB. Bagi ibu menyusui, hendaknya cuci tangan pakai sabun sebelum memegang bayi atau mengolah makanan. Ini penting karena umur bayi balita rentan terhadap penyakit infeksi. Jangan lupa pula setelah memegang binatang, segera cuci tangan pakai sabun.
Baca juga: Jangan Anggap Sepele, Perhatikan Hal-hal Ini Saat Cuci Tangan
(vit/vit)




















































